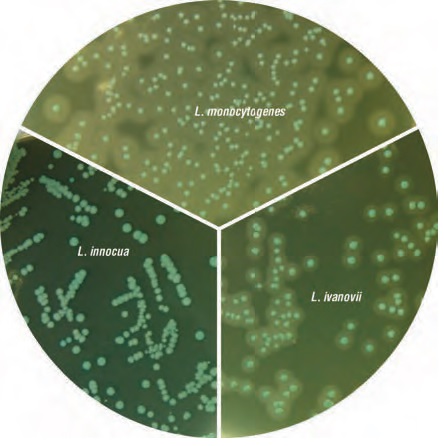
李斯特菌显色培养基的应用
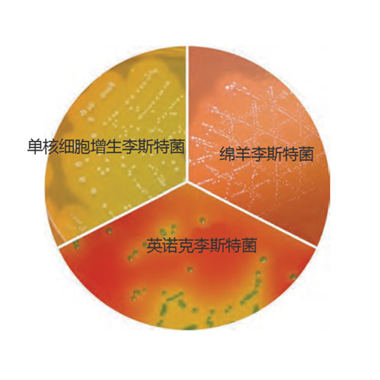
李斯特菌显色培养基的应用
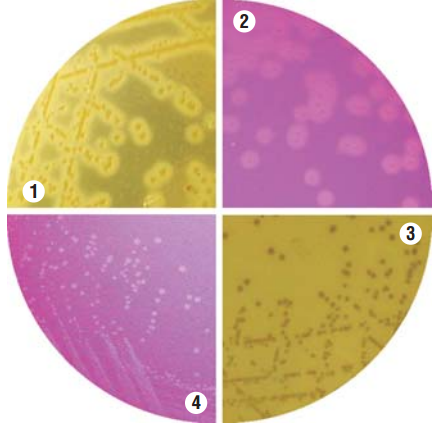
李斯特菌显色培养基的应用
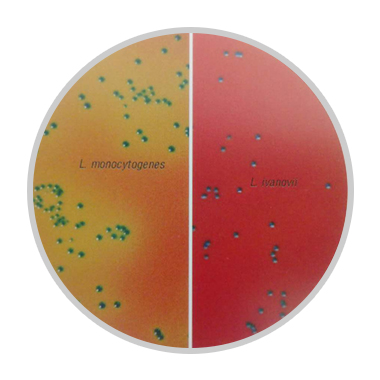
李斯特菌显色培养基的应用

9 年
手机商铺
公司新闻/正文
241 人阅读发布时间:2018-10-16 16:17
李斯特菌属( Listeria.spp) 经常存在于各种动物和环境中,来源于土壤和水中的李斯特菌可能污染人类消费品,特别是即食食品。与其他常见致病菌相比,单核细胞增生李斯特菌的感染率虽然较低,但致死率高达 20%~50%。因此,高效精确地从食品等样品中分离和鉴别出单核细胞增生李斯特菌,对食品质量控制和疾病预防治疗有重要意义。
ISO、FDA 及我国卫生部推荐的标准方法和替代方法是用 PALCAM 和显色培养基进行检测和分离。传统的PALCAM 经过长期的应用验证,能有效地分离李斯特菌,但无法区分致病和非致病的李斯特菌,另外许多七叶苷阳性的菌也会产生一些假阳性及干扰。
近年来兴起的李斯特菌显色培养基,通常是采用属特异性β-葡萄糖苷酶和磷脂酰肌醇或胆碱酶显色技术。平板制备时对磷脂酰肌醇或胆碱配套试剂要求严格,温度过高会产生絮状物,难以观察到菌落特征,温度过低又易凝固而不能再次加热溶解。
实验过程中显色培养基的质量,直接决定实验的成败。推荐使用进口产品,HiMedia公司(国际知名微生物培养基生产商)生产的显色培养基,其他显色培养基厂家比较,HiMedia显色培养基在普通显色培养基的基础上改良,形成自己独特产品,显色效果区分明显,特异性较强,产品种类更丰富。如对于李斯特菌的检测,目前有5款产品可以选择。
产品1:单增李斯特氏菌显色培养基(货号:MV1540)
选择鉴别性分离单核细胞增生李斯特氏菌。
它的特点是可区分单增李斯特氏菌与英诺克李斯特氏菌,但无法区分单增李斯特氏菌和伊氏李斯特氏菌。该培养基完全符合我国食品安全检测标准GB4789.30-2016,国标优选 ALOA法。
原理:依据李斯特菌特有的β-葡糖苷酶及磷脂酰肌醇特异性磷脂酶C(PIPLC)活性。

产品2:HiCrome单增李斯特氏菌鉴别琼脂基础(货号:M2009)
与货号MV1540不同的是依据李斯特菌的β-半乳糖苷酶和磷脂酰胆碱特异性磷脂酶C(PCPLC活性)注:不是PIPLC
产品3:HiCrome单增李斯特氏菌快速鉴别琼脂基础(货号:M1924)
该培养基适用于快速鉴定和鉴别单增李斯特菌,并与其他李斯特菌菌种区分。
原理:除了依据 “β-葡糖苷酶”、和“PIPLC活性”外,增加了“鼠李糖发酵”的检测,从而对绵羊李斯特菌(伊氏李斯特氏菌)、英诺克李斯特菌和单增李斯特氏菌三者能够进行区分。
产品4:单增李斯特氏菌验证琼脂基础(MV1552)
用于从临床和食品样本选择性分离鉴别单核细胞增生李斯特菌。
原理:依据PIPLC活性和α-甲基-D-甘露糖苷的发酵。
它不是显色培养基,但能区分单增李斯特氏菌、伊氏李斯特氏菌和英诺克李斯特氏菌。
产品5:HiCrome李斯特氏菌琼脂基础(M1417,M1417F)
从食品和临床样本中快速选择、鉴别、鉴定李斯特菌。
M1417、M1417F均能鉴别出李斯特菌。此外,M1417还能鉴别是否发酵鼠李糖,M1417F能鉴别是否发酵木糖,因而能区分伊氏和单增。
实验过程中,可以根据具体的需求进行选择,HiMedia公司生产的显色培养基与传统培养基相比,克服了传统培养基在各种细菌分离、鉴别、计数等操作过程中比较复杂(需要有经验的技术人员)、耗时较长、敏感性低和特异性差的缺点。
Himedia显色培养基在检测细菌时,通常培养24小时通过观察菌落颜色即能用肉眼对细菌进行定性或定量分析,既缩短了检测时间,减少了生化鉴定的过程,极大提高工作效率。
威正翔禹|北京缔一生物始终专注于细胞培养,制药,疫苗生产,生物医疗,微生物检测、培养等领域。为国内科研生产用户提供:细胞培养用进口血清,培养基,支原体检测祛除试剂,微生物培养基和检测试剂,疫苗质控试剂,蛋白稳定剂,国际标准级增鲜剂,蛋白胨和蛋白水解物等原料。